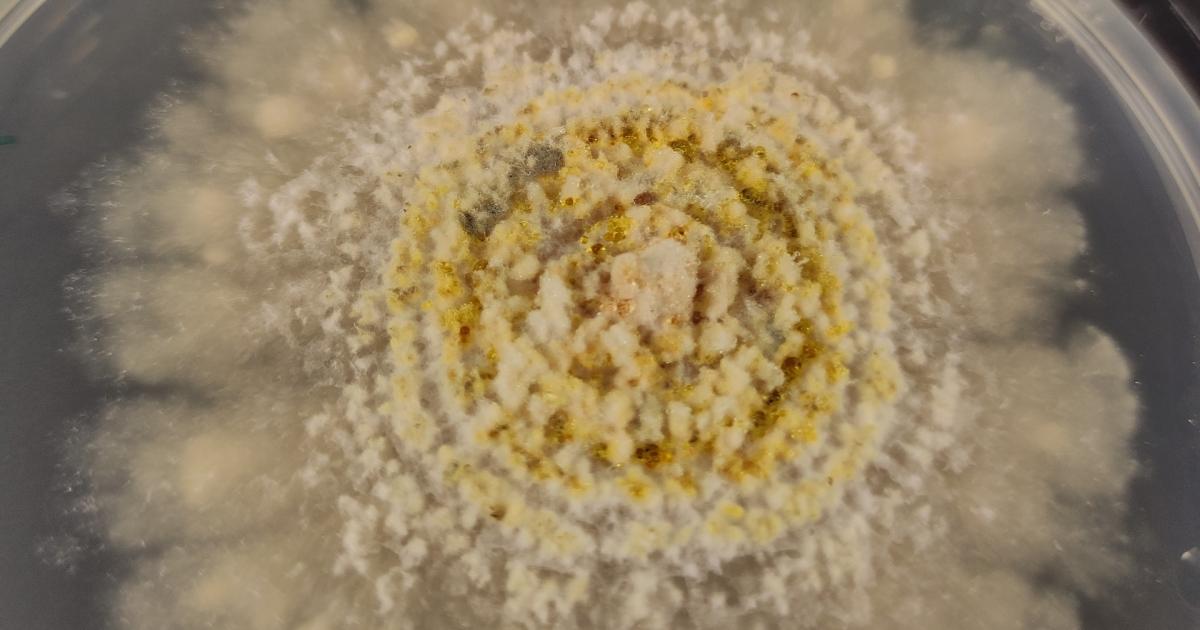
UniOulu's tweet card. Tutkimus valottaa puiden symbioosia eli vuorovaikutussuhteita mikrobien kanssa stressaavissa olosuhteissa.

#mikrobit kết quả tìm kiếm
Voihan pöpö! #Mikrobit eivät lihota meitä, mutta niiden #aineenvaihdunta'tuotteilla on monia vaikutuksia mm. #ruokahalu'un. #ravitsemuspäivät2018

Kannatti tilata @tiede_lehti! Uusimmassa numerossa on artikkeli siitä, mitä #viemäri kertoo elämästä. "Jätevesitutkimus on nyt vasta kalpea aavistus siitä, missä kaikessa sitä voisi hyödyntää." Töihin sit vaan! #mikrobit #huumeet #antibioottiresistenssi #lääkeaine #elintavat

Kodlamayı, programlamayı sevdirerek öğretmeyi hedefleyen eğitim günümüz bugün @bbc_microbit @mikrobitproject @tr21trakya #mikrobit #mikrobitproject
.@VTTFinland kehittää muovia hajottavista mikrobeista ratkaisua merien muovijäteongelmaan #biotekniikka #mikrobit #muovit #biotalous #kiertotalous vtt.fi/medialle/uutis…

Hanna-Leena Alakomi VTT:ltä kertoo tv-haastattelussa marjojen kyvystä estää haittamikrobien kasvua. Ks. @yleareena : areena.yle.fi/1-4257020#auto… (28:50 min ) #marjat #mikrobit #antibioottiresistenssi

Rakkaudesta mikrobeihin syntyi tämäkin #Qvidja olutkokeilu. Onkohan asiaa missä #mikrobit eivät olisi kingejä? 🦠 Aina ilo tehdä maailman parhaiden (myös ihmisten) kanssa yhteistyötä. Jos #olut on hifistelyjuttusi, älä hättäile, selvitellään just miten halukkaat saavat tätä.



Professori Annamari Ranki kertoo ihon hyvistä ja pahoista mikrobeista. Tiesitkö että meissä elää miljoona miljoonaa mikrobia! Osa on normaaleja ja osa taudinaiheuttajia. Älä pese ihoa liikaa bakteerit kouluttavat immuunipuolustustamme #iho #mikrobit #StudiaMedicina @amchelsinki


#mikrobit kodlama programımız başladı. 5 proje ile bugünü tamamladık.Bize gelemeyenler,uzakta olanlar makecode.microbit.org üzerinden evde kendileride yapabilirler. @abakuskitap Yayınlarından çıkan #ümituğurlu tarafından hazırlanan mikro:bit kitabı ile daha verimli yapılabilir
Neljäsosa luonnon monimuotoisuudesta löytyy maan alta, kertoo @SKankaanrinta @BSAG_ #mikrobit #maaperä #Itämeri #ilmastonmuutos #ravinteetkiertoon

Tänään #TerveysSummit'issa ⭐️Elias Hakalehto #mikrobit ⭐️Jouni Simola @Virhory #vesistöt #vapautavirrat ⭐️Juha-Pekka Saarelainen #mikromuovit ⭐️Teemu Syrjälä #luontosuhde ⭐️Saara Kankaanrinta #Itämeri #luonnonsuojelu #ympäristö @BSAG_ @SKankaanrinta terveyssummit.fi

Sisäilmaoireista ei voi syyttää pelkästään toksiineja. Tule kuuntelemaan seminaaria aiheesta ensi tiistaina 20.2. Kuopioon. Lisätietoja: thl.fi/tiistaiseminaa… #sisäilma #mikrobit #toksiinit #tiistaiseminaarit #ympäristöterveys

Olipas kiva yllätys löytää tulevaisuuden ruoasta loistava juttu uusimmasta Kemia lehdestä. @ReettaKivela @AgriForHelsinki ja @LauriReuter @FoodTechVC reseptiin kuuluvat kohtuullistaminen, #mikrobit ja aimo annos kemiaa! #ruoka #kemia #kemialehti @SKS_Chemistry

Vakavien haasteiden selättämiseen tarvitaan yhteistyötä ilmaston muutoksen hillinnässä ja muutokseen sopeutumisessa Riskienhallintaa kehitettävä sanoo @jhusukallio #kalataudit #lohi #mikrobit #kasvinterveysvuosi #sieto #IPCCRAPORTTI @mmm_fi @meteorologit @lvmfi @yministerio

Tiesitkö, että 🌳puuainesta voidaan kasvattaa tankissa? 🍄 sienien rihmastoista voidaan valmistaa "nahkaa" 🍩mikrobien avulla voidaan valmistaa ruokaa suoraan ilmasta? @NPulkkis keynote biotekniikan kärjistä kuultavissa @ulosutout issa vielä viikon ajan! #ulos2021 #mikrobit

#Teknologia'n kehitys on yksi @justfood_stn murrospoluista kohti vähähiilistä ruokajärjestelmää. @tiede_lehti ennusteessa vuonna 2060 #sisäviljelmät, #mikrobit, #bioreaktorit, #eläinsolut, #syanobakteerit, #viherlevät ja #hyönteiset on valjastettu ruoantuotantoon.

”Jos biologisen elämän suojelulle löytyy välittömiä terveyskysymyksiä, alkavatko ympäristökysymykset kiinnostaa?” -Tari Haahtela @DuodecimFi . #NesslingNest aamukahveilla kuulemme @SYKEinfo tutkija Jenni Lehtimäkeä: suojaako #elonkirjo elintasasairauksilta?#mikrobit #terveys

Päivä @Yleisradio kanssa pelloilla, laitumilla ja maanparannuskasoilla (kuidut, kakka) lähiotoksia kuvaten. #Mikrobit, #madot #multavuus ja #biodiversiteetti pääroolissa! #soilhealth #CarbonAction (Sitten rutiinilabrat omasta terveydestä - mikrobien voimaa ihmisessäkin).




Jäsen, @Duodecimlehti nro 19 on ilmestynyt! Paljon kiinnostavia aiheita mm. #hoitosuositukset ja suoliston #mikrobit. Lue, miksi rokotetutkin voivat saada #koronavirus’tartunnan ja minkälaiset #korona'näkemykset ovat yhteydessä rokotushalukkuuteen. ➡ bit.ly/uusin_d-lehti

Mitä sinun tulee tietää hengityssuojaimista. #päivitätietosi #mikrobit #ilmahygienia @hsfi @iltalehti_fi @hblwebb @HUS_fi
Shoutout to @TheWHN for putting together an excellent, science-based Q&A on why many of us are still masking😷 "Yes, We Continue Wearing Masks—Here’s Why: Common Questions Answered." Source: whn.global/yes-we-continu…

📣 "Kaupungit on rakennettu niin tiiviiksi, että se vaarantaa ihmisten terveyden, sanoo vauvojen ja lasten immuunijärjestelmän kehittymistä tutkinut #JenniLehtimäki." #Terveys #Mikrobit #Riskitekijä #TerveysvaikutustenArviointi #Asuminen #Vauvat #Lapset hs.fi/alueet/art-200…
Kylpypyyhkeen ahkera pesu on turhaa: ”Ei ole syytä yrittää päästä ihon mikrobeista eroon” apu.fi/artikkelit/mit… #hygienia #bakteerit #mikrobit #puhtaus #pyyhe #tiede

Tšernobylin punaisen metsän koivuja onnistuttiin tutkimaan ukrainalaisten, suomalaisten ja eurooppalaisten tutkijoiden yhteistyönä. Yhteistyössä tarkastellaan ydinonnettomuuden jatkuvia vaikutuksia ympäristöön. #UniOulu #Tsernobyl #mikrobit #symbioosi oulu.fi/fi/uutiset/tse…
Erittäin mielenkiintoista. #mikrobit #bakteerit #keittiö #siivous #hygienia hs.fi/tiede/art-2000…
Mikrobeja sisältävän maaperän syömisellä voi olla merkittävä vaikutus terveyteemme, mutta terveyttä edistävien mikrobien monimuotoisuus puuttuu tänä päivänä lautaseltamme. #ravintosuositus #terveys #mikrobit #maaperä luke.fi/fi/uutiset/rav…

Tuoreen katsauksemme mukaan mikrobeja sisältävän maaperän syöminen voisi edistää suolistomikrobiston ja immuunipuolustuksen kehittymistä sekä vaikuttaa parantavasti mielenterveyteen. #terveys #mikrobit @Akatemia_STN @akisink @MarjaRoslund Lue lisää: biwe.fi/julkaisu/ravin…
Vinkkejä pihapuiden hyötykäyttöön! Lue @akisink ja Minna Harjun ideoita, mitä tehdä kaadetuista pihapuista ja niiden oksista omalla pihalla. #pihasuunnittelu #monimuotoisuus #mikrobit #pölyttäjät #kevät yle.fi/a/74-20080994
"Jo aiemmin on tiedetty, että synnytyksen aikana äidille annettu antibiootti vaikuttaa lapsen #suolisto-n mikrobiympäristön kehittymiseen." - Aivan (,täst on puhuttu jo väh 10 v.) ; Samaten, vaikutus varhasimpien 10 ikä-v. ajalta. #antibiootit #mikrobit ; yle.fi/a/74-20075857
#Antibiooteille #vastustuskykyisiksi tulleet #mikrobit tappavat Lancet-lehdessä julkaistun laskelman mukaan vuodessa 1,3 miljoonaa ihmistä, jotka jäisivät henkiin, jos antibiootit eivät olisi menettäneet tehoaan. - Antibioottiresistenssin uhrien määrä on kasvussa. Vuonna 2050…
#Luomupäivät toisen päivän rinnakkaisohjelmissa mm. porkkanapellon hyvät, pahat ja rumat #mikrobit. @TSuojala kertoi että tautien esiintymiseen vaikuttaa erityisesti hyvien mikrobien elinmahdollisuuksien parantaminen.
St Andrewsin yliopiston tutkimusryhmä on löytänyt uuden, tieteelle aiemmin tuntemattoman SAM-AMP-molekyylin. Mikrobeissa elävä, uusi molekyyli toimii "hätäsignaalina" ja havaitsee viruksia. #tutkimus #mikrobit laakarilehti.fi/tieteessa/mikr…
Äidin #mikrobit voivat vaikuttaa kehittyvän sikiön elimistöön. "Tutkimuksemme tuo uutta tietoa mikrobiston merkityksestä ja mekanismeista, joilla mikrobisto vaikuttaa yksilönkehitykseen ja raskauteen" sanoo @MikaelNiku helsinki.fi/fi/uutiset/ter… #eltdk #mikrobisto #perustutkimus

🥼😷#Lääkärien suojavaate on aina #valkoinen takki. Lyhyt tai pitkä. Epähieno kysymys: Onko suojavaate epämukava käytössä vastaanotolla, koska moni lääkäri unohtaa takin auki! Voisiko suojavaate olla myös värillinen?😃 #mikrobit #suojavaate
Vaasan HAO ”Tällä hetkellä akkuteollisuudessa ei ole sulfaattipoisto teknologiaa, jonka katsottaisiin olevan parasta käyttökelpoista tekniikkaa” . #MUSTPureWaterTechnology poistaa #sulfaatti #mikrobit #PAH #PFAS #raskasmetallit #jätevesi stä @ramboll_fi @AFRYSuomi @FCG_Group
Prof. Frimanin hankkeessa tuotetaan yhteistyössä @NeovaGroup kanssa uutta tietoa siitä, miten turpeen hyödyt voidaan siirtää vaihtoehtoisiin kasvatusmateriaaleihin. Tutkimuksen keskiössä ovat turvemikrobiyhteisöt sekä kasvien ja mikrobien vuorovaikutukset. #mikrobit #turve
Olipas kiva yllätys löytää tulevaisuuden ruoasta loistava juttu uusimmasta Kemia lehdestä. @ReettaKivela @AgriForHelsinki ja @LauriReuter @FoodTechVC reseptiin kuuluvat kohtuullistaminen, #mikrobit ja aimo annos kemiaa! #ruoka #kemia #kemialehti @SKS_Chemistry

Terveille vapaaehtoisille annettiin 6 ylimääräistä grammaa suolaa kahden viikon ajan,mikä 2x heidän suolan kulutuksen. - Lactobacillus -bakteerien määrä vähentyi rajusti – ja koehenkilöiden verenpaine nousi.. #Suoliston #mikrobit ovat mukana monessa .. hs.fi/tiede/art-2000…
Voihan pöpö! #Mikrobit eivät lihota meitä, mutta niiden #aineenvaihdunta'tuotteilla on monia vaikutuksia mm. #ruokahalu'un. #ravitsemuspäivät2018

.@VTTFinland kehittää muovia hajottavista mikrobeista ratkaisua merien muovijäteongelmaan #biotekniikka #mikrobit #muovit #biotalous #kiertotalous vtt.fi/medialle/uutis…

Tiesitkö, että 🌳puuainesta voidaan kasvattaa tankissa? 🍄 sienien rihmastoista voidaan valmistaa "nahkaa" 🍩mikrobien avulla voidaan valmistaa ruokaa suoraan ilmasta? @NPulkkis keynote biotekniikan kärjistä kuultavissa @ulosutout issa vielä viikon ajan! #ulos2021 #mikrobit

Neljäsosa luonnon monimuotoisuudesta löytyy maan alta, kertoo @SKankaanrinta @BSAG_ #mikrobit #maaperä #Itämeri #ilmastonmuutos #ravinteetkiertoon

Kannatti tilata @tiede_lehti! Uusimmassa numerossa on artikkeli siitä, mitä #viemäri kertoo elämästä. "Jätevesitutkimus on nyt vasta kalpea aavistus siitä, missä kaikessa sitä voisi hyödyntää." Töihin sit vaan! #mikrobit #huumeet #antibioottiresistenssi #lääkeaine #elintavat

Akkreditoitujen laboratorioanalyysien tarjonta laajenee Työterveyslaitoksella. Saimme rakennusmateriaalinäytteiden kvantitatiiviselle PCR-analyysille akkreditoinnin. @tyoterveys @FIOH #sisäilma #mikrobit

Luonnon kiertokulku. Aina yhtä ihmeellistä. Talven jäljiltä kompostissa kaunista tuoksuvaa multaa. Kiitos maan matoset, #mikrobit ja muut ötökät, olette taas olleet ahkeria. #KädetMultaan

Professori Annamari Ranki kertoo ihon hyvistä ja pahoista mikrobeista. Tiesitkö että meissä elää miljoona miljoonaa mikrobia! Osa on normaaleja ja osa taudinaiheuttajia. Älä pese ihoa liikaa bakteerit kouluttavat immuunipuolustustamme #iho #mikrobit #StudiaMedicina @amchelsinki


Kun metsäteollisuuden sivuvirrat johdetaan peltoon, saadaan terveitä kasveja ja puhtaampia vesistöjä. Kaiken takana ovat mikrobit. #kasvinterveysvuosi #mikrobit #metsä #maatalous #sivuvirrat #hiili luke.fi/mt_metsateolli…

Tänään #TerveysSummit'issa ⭐️Elias Hakalehto #mikrobit ⭐️Jouni Simola @Virhory #vesistöt #vapautavirrat ⭐️Juha-Pekka Saarelainen #mikromuovit ⭐️Teemu Syrjälä #luontosuhde ⭐️Saara Kankaanrinta #Itämeri #luonnonsuojelu #ympäristö @BSAG_ @SKankaanrinta terveyssummit.fi

Sisäilmaoireista ei voi syyttää pelkästään toksiineja. Tule kuuntelemaan seminaaria aiheesta ensi tiistaina 20.2. Kuopioon. Lisätietoja: thl.fi/tiistaiseminaa… #sisäilma #mikrobit #toksiinit #tiistaiseminaarit #ympäristöterveys

Rakkaudesta mikrobeihin syntyi tämäkin #Qvidja olutkokeilu. Onkohan asiaa missä #mikrobit eivät olisi kingejä? 🦠 Aina ilo tehdä maailman parhaiden (myös ihmisten) kanssa yhteistyötä. Jos #olut on hifistelyjuttusi, älä hättäile, selvitellään just miten halukkaat saavat tätä.



Vakavien haasteiden selättämiseen tarvitaan yhteistyötä ilmaston muutoksen hillinnässä ja muutokseen sopeutumisessa Riskienhallintaa kehitettävä sanoo @jhusukallio #kalataudit #lohi #mikrobit #kasvinterveysvuosi #sieto #IPCCRAPORTTI @mmm_fi @meteorologit @lvmfi @yministerio

#Teknologia'n kehitys on yksi @justfood_stn murrospoluista kohti vähähiilistä ruokajärjestelmää. @tiede_lehti ennusteessa vuonna 2060 #sisäviljelmät, #mikrobit, #bioreaktorit, #eläinsolut, #syanobakteerit, #viherlevät ja #hyönteiset on valjastettu ruoantuotantoon.

”Jos biologisen elämän suojelulle löytyy välittömiä terveyskysymyksiä, alkavatko ympäristökysymykset kiinnostaa?” -Tari Haahtela @DuodecimFi . #NesslingNest aamukahveilla kuulemme @SYKEinfo tutkija Jenni Lehtimäkeä: suojaako #elonkirjo elintasasairauksilta?#mikrobit #terveys

Olipas kiva yllätys löytää tulevaisuuden ruoasta loistava juttu uusimmasta Kemia lehdestä. @ReettaKivela @AgriForHelsinki ja @LauriReuter @FoodTechVC reseptiin kuuluvat kohtuullistaminen, #mikrobit ja aimo annos kemiaa! #ruoka #kemia #kemialehti @SKS_Chemistry

Something went wrong.
Something went wrong.
United States Trends
- 1. Peggy 30K posts
- 2. Zeraora 12.2K posts
- 3. Sonic 06 1,862 posts
- 4. Berseria 4,114 posts
- 5. Cory Mills 25.5K posts
- 6. Randy Jones N/A
- 7. #ComunaONada 2,641 posts
- 8. Dearborn 359K posts
- 9. $NVDA 43.3K posts
- 10. Luxray 2,084 posts
- 11. Ryan Wedding 2,262 posts
- 12. #Wednesdayvibe 2,801 posts
- 13. #wednesdaymotivation 7,834 posts
- 14. Xillia 2 N/A
- 15. International Men's Day 75.7K posts
- 16. Good Wednesday 37.1K posts
- 17. #CurrysPurpleFriday 11K posts
- 18. Abyss 12.1K posts
- 19. Winter Classic 1,050 posts
- 20. Cleo 3,047 posts